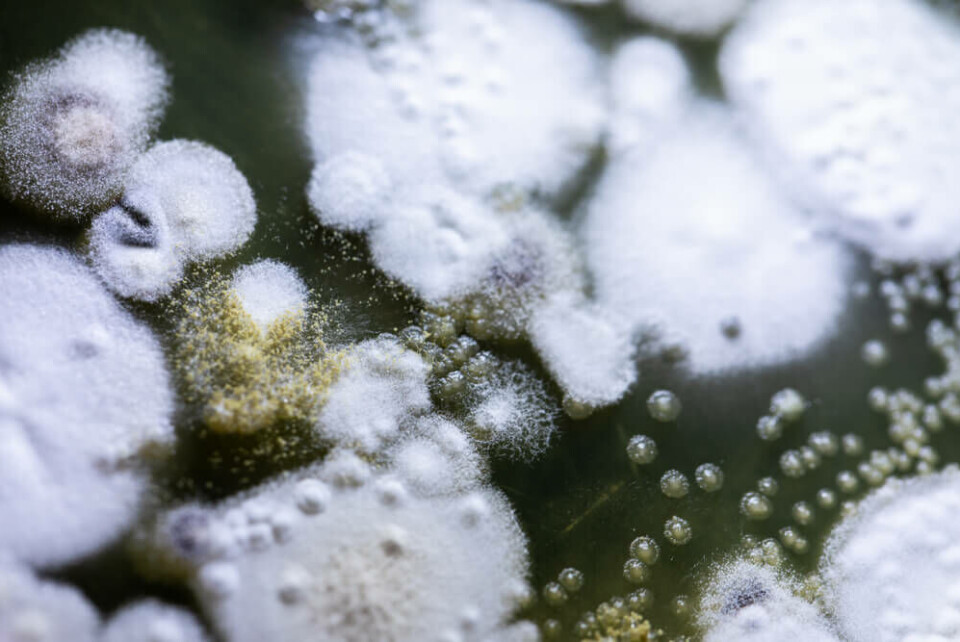

Slår muggalarm på Gran Canaria: – Alvorlig
– Folk blir dårlige, advarer norsk ekspert på inneklima.
Gran Canaria er som kjent et populært ferieparadis for mange nordmenn. Hit reiser folk i flokk for det gode, helsebringende klimaet.
Samtidig bor folk flest i direkte helsefarlige boliger mens de er på øya, viser tall fra den norske bedriften Fixit, som jobber med mugganalyse, desinfisering og utbedring av fuktproblemer på øya.
Den norske mugg- og desinfeksjonseksperten Jan-Erik Fredriksen introduserte i sin tid den første tørrbestøvingen med hydrogenperoksid for desinfisering på det norske markedet.
Han har også bidratt i utvikling av metodikken som i dag brukes på flere sykehus og helseinstitusjoner og er publisert i blant andre Journal of Hospital Infections.
Klar advarsel
Nå advarer Fredriksen og Fixit nordmenn på Gran Canaria mot den skjulte faren fukt og mugg utgjør i boligene.
– Det jeg har sett her nede når jeg er ute å tar miljøprøver, er at 75 - 80 prosent av boligene har et sykt inneklima. Folk blir dårlige av å bo der og puste muggsoppsporer. Man kan bli alvorlig syk, advarer han.
Årsaken til de store muggfunnene i nordmenns boliger? Fuktighet.
Fukt er et utbredt problem i boligene på Kanariøyene, og mangel på ventilasjon er en av de største synderne.
– Årsaken til problemet er alltid fuktighet i en eller annen form. Mange hus her nede har alt for dårlig ventilasjon. De har dusj i leilighetene uten ventilasjon og når man har dusja tørker ikke folk vekk fukten, så det blir liggende, forklarer han.
Når det skjer blir det raskt grobunn for skadelige muggsoppsporer. I tillegg er muren som brukes til å bygge boliger på Kanariøyene mer porøs enn den som brukes i Norge.
– I tillegg er det jo nattkondensering og den typen mur som brukes her er mer porøs enn den vi har i Norge. Det betyr at du kan fåkapillært oppsug når fuktigheten blir høy, så det trekkes inn i muren. Kombinert med høy varme vil det danne grobunn for muggvekst. Det har ingenting med at det ikke er rent hos folk å gjøre, forklarer Fredriksen.
Dårlige vaner
Men det er ikke bare dårlig byggepraksis som fører til problemene nordmenn tilkaller Fixit for. Det er også dårlige vaner som er enkle å unngå.
– Når folk drar hjem etter å ha vært her, er det siste de gjør å vaske klær. Da henger de gjerne ut søkkvåte klær og sengetepper i stua, klasker igjen døra og reiser hjem til Norge. Da har de lagt igjen en bombe med fuktighet, advarer Fredriksen.

Kan gi helseplager
Konsekvensene av et slikt innemiljø kan være alvorlige for helsen. Fenomenet er kjent som «Sick building syndrome» og kan gi symptomer som hodepine, kløe i øynene, søvnproblemer, tap av matlyst, kvalme, svimmelhet og generell utmattelse. Muggsopp kan også føre til lunge- og astmaproblemer, ifølge Fredriksen.
Han får støtte fra både Verdens helseorganisasjon og det norske Folkehelseinstituttet, som begge understreker at man er utsatt for økt risiko for luftveissykdom, infeksjon og forverring av astma i muggutsatte boliger.
Usynlig
At problemet ofte er usynlig gjør at mange ikke oppdager problemet før det er for sent.
– Muggsoppen trenger du ikke å se en gang. Den vokser ved at den frigir sporer. Hvis du mikroskoperer mugg, ser du at det ser ut som et glassfiberaktig teppe og mellom disse strukturene kommer det opp og de slipper ut bittesmå sporer som flyr rundt i lufta, forteller Fredriksen.
Ifølge Fredriksen kan hundretusener av disse sporene seile rundt i boligen. Når de finner nye områder med fukt slår de seg ned og vokser videre.
Han mener muggsopp er en større helseutfordring enn Radon er i Norge.
– I Norge er det krav om sertifikat for å leie ut sokkelleiligheter i forhold til Radon, men det er ikke slike krav om muggsopp, selv om det er mye mer alvorlig. Halvparten av de som dør av sepsis dør av soppinfeksjon. Det slår ut på mange måter, sier han.
Dette bør du gjøre om du mistenker mugg

Det første skrittet som må gjøres hvis man mistenker mugg i boligen, er en analyse av mugg- og bakterieforholdene ved hjelp av laboratorietester som tar rundt seks dager.
– Når vi inkuberer dette i en ukes tid ser vi hvor mye mugg det er, hva slags type mugg det er og hvilke helseaspekter som er rundt dette. Vi har også samarbeid med Det norske legesenteret i Arguineguín og har brukt dette for å sanere praksisen der nede under pandemien. Dette er også supereffektivt på virus, sier Fredriksen.
Bestøving med hydrogenperoksid er en av de mest effektive metodene for å ta knekken på muggsopp. Samtidig påpeker Fredriksen at man først må gjøre noe med årsaken til fukten og muggveksten.
– Så kan vi behandle for å nullstille miljøet med bestøvelsesteknologi basert på hydrogenperoksid. Vi kjører tre runder i leiligheten. Det er egentlig overkill, men det var noe vi gjorde sammen med Ullevaal sykehus for å ta knekken på sporer og multiresistente bakterier, forklarer han.
–Så bør man etterkontrollere og følge med. Det er smart å gjøre, avslutter Fredriksen.